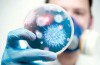
Genital siğiller kanser yapar mı?

Genital siğiller kanser yapar mı?
2014.08.10 23:41
Son Güncellenme: 2014.08.10 23:41
-
GÜNDEM
Güçlükle fark edilecek kadar küçük bir yapıdan, karnabahar görünümlü yaygın alanlara kadar değişik büyüklüklerde ciltte kabarık olarak ortaya çıkan genital siğiller, hem kadınlarda hem de erkeklerde görülebiliyor. Ağrı hissettirmeyen bu siğillerin sorumlusu ise cinsel temas ile bulaşan Human Papilloma Virüsü (HPV).
Kadın Hastalıkları ve Doğum Uzmanı Op. Dr. Gonca Saraç, “Bazı HPV tipleri, kanser açısından yüksek risk taşıyabiliyor ve rahim ağzında kanserin öncü değişikliklerine, rahim ağzı, penis ve anüs kanserlerine neden oluyor. Bazı HPV tipleri ise kanser riski taşımadan sadece genital siğillere neden olabiliyor. Bu siğillerin yüzde 90’ından HPV tip 6 ve 11 sorumlu tutulurken bu tipteki virüsler onkolojik potansiyel açısından düşük riskli grupta kabul ediliyor. Ancak siğil bulaşmış bir kişide, rahim ağzı kanseri yapan yüksek riskli HPV örneği gibi cinsel yolla bulaşan diğer hastalık sebeplerinin aynı anda bulunma ihtimali artıyor.” diyor.
HPV nasıl bulaşır, nasıl fark edilir?
• HPV bir kişiden diğerine cinsel ilişki ile (vajinal, anal veya ağızdan) geçer. Kişi, vücudunda gözle görülür siğil taşımasa da, HPV bulaştırabilir.
• Siğiller, HPV bulaşmasından 6 hafta ile 6 ay arasında görülmeye başlar. Kişi siğili olduğunu yıllarca fark etmeyebilir.
• Genital siğil ve HPV ile temas etmiş herkeste siğil görülmeyebilir.
Genital siğillere neden olan bir virüs olduğu için, tedavi ile siğiller ortadan kaldırılsa dahi, vücutta HPV’nin yok edilmesi maalesef mümkün olmuyor. Bu nedenle siğil tedavisine rağmen, yüzde 50-73 oranında tekrarla karşılaşılabiliyor. Ancak, bazı vakalarda siğiller tedavisiz de gerileyebiliyor.
Genital siğilden korunmanın tek yolu cinsel ilişkide bulunmamak. Teorik olarak, sadece hastalık taşımadığı bilinen tek partnerle birlikte olunması halinde risk ortadan kalkıyor. Ancak, bir kişinin HPV taşımadığını (HPV uyku döneminde ise) gösterebilmenin yolu maalesef yok. Cinsel yaşamı aktif kişilerin yüzde 50’sinin hayatlarının bir döneminde HPV ile karşılaştığı kabul ediliyor. HPV enfeksiyonu riski en yüksek grup, enfeksiyon cinsel aktiviteye paralellik gösterdiğinden 17-33 yaş grubu. Kadın veya erkek kondomları riski bir miktar düşürse de, ciltten geçiş açıkta kalan alanlardan da söz konusu olabileceği için bulaşmaya tamamen engel olmuyor. Genital siğil yapan HPV tiplerine karşı aşılanmak ise korunmaya yardımcı oluyor.